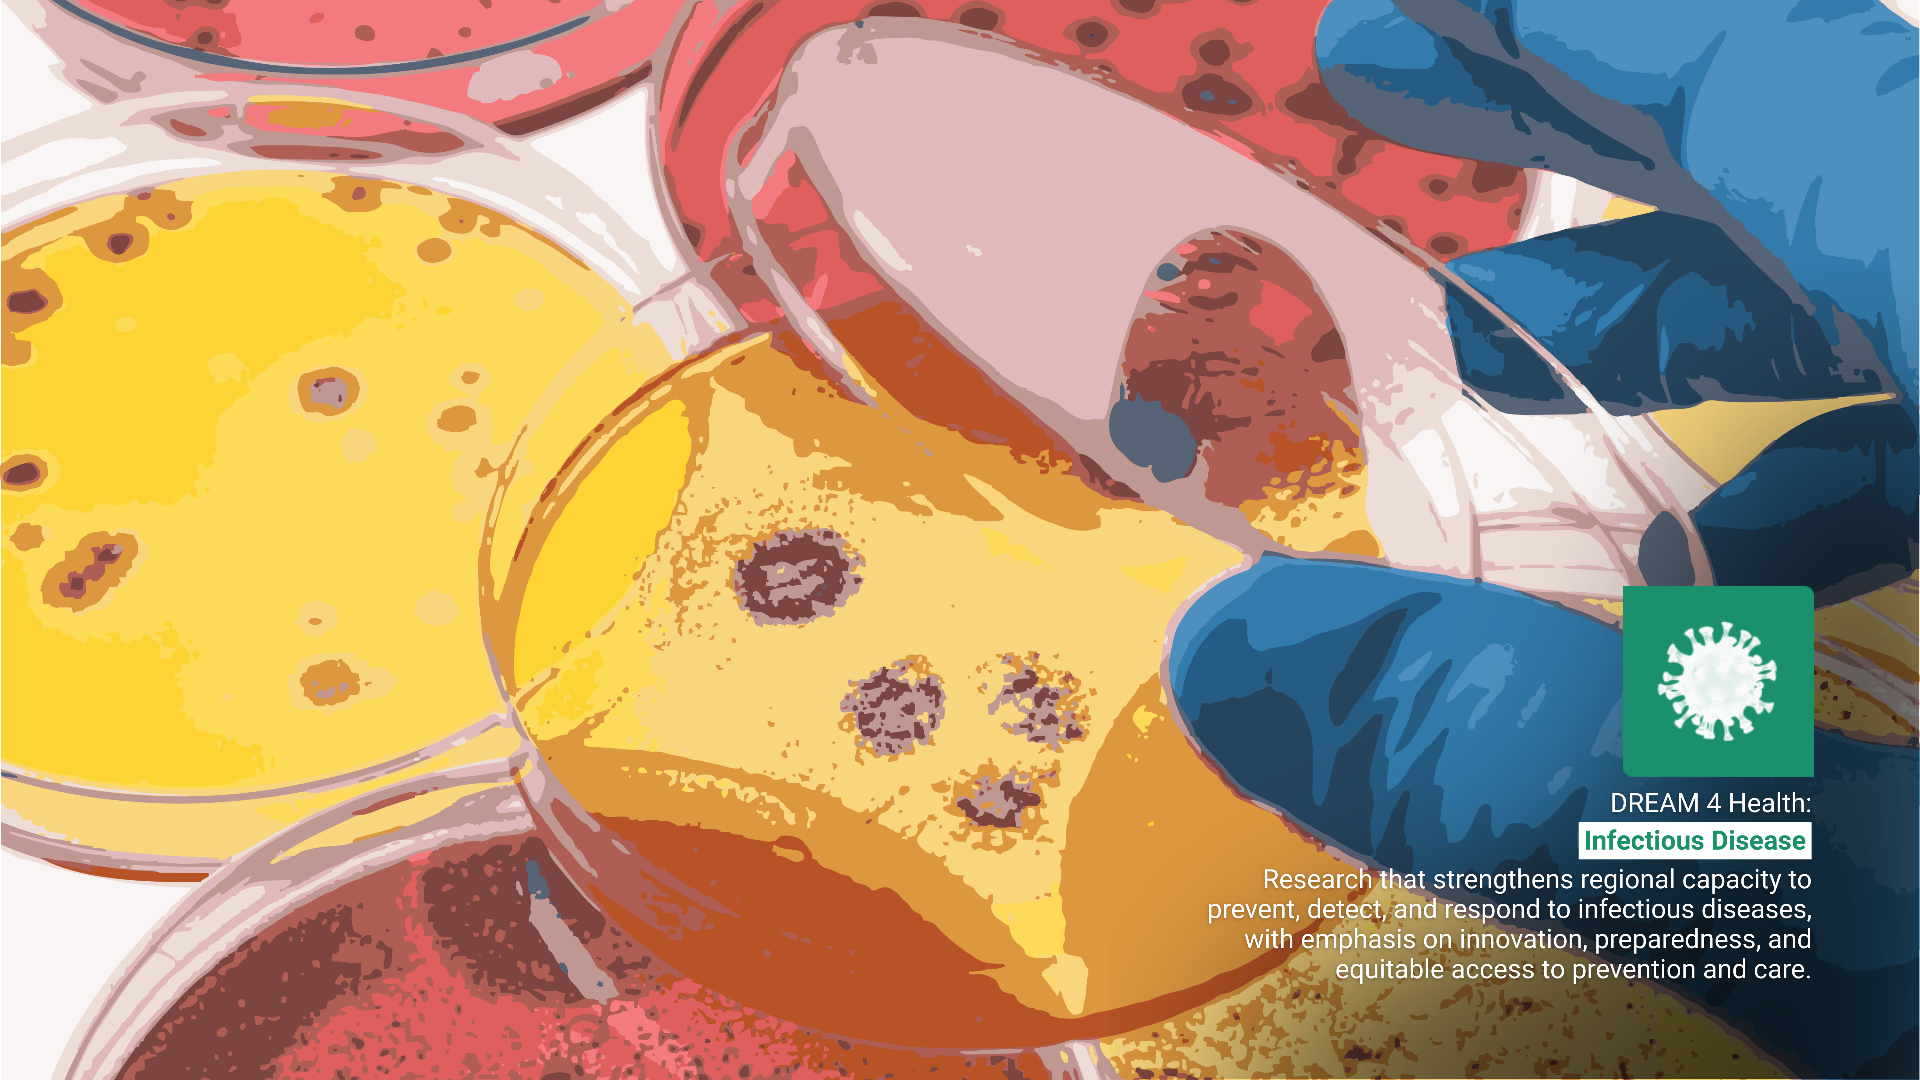
An Enduring Epidemic: Infectious Disease in Southeast Asia

An Enduring Epidemic: Infectious Disease in Southeast Asia
Infectious diseases remain a major health and development challenge in Southeast Asia. The burden of communicable diseases is disproportionately high in low- and middle-income countries (LMICs), with mortality rates and years of life lost from infectious diseases roughly ten times higher than in high-income countries (Pagès et al., 2018). Most LMICs in the region are located in tropical or subtropical areas, where vector-favorable climates, combined with poverty and limited access to improved water, sanitation, and healthcare, exacerbate vulnerability to infectious diseases (Pagès et al., 2018).
Public health strategies for controlling infectious diseases can be categorized by prevention level. Control efforts often combine interventions across different levels, implemented according to the stage of disease. At the individual level, targeted actions form a logical cascade that is complemented by broader community-level interventions (Pagès et al., 2018). Despite public health successes in wealthier regions, infectious diseases continue to heavily affect populations in LMICs (Roche et al., 2018).
In recent decades, several diseases have emerged or reemerged, including AIDS, West Nile fever, and Legionnaires’ disease, while previously controlled diseases such as malaria, Lyme disease, and tuberculosis have resurged (McFee, 2018). In the twentieth century, increased public health knowledge and interventions significantly reduced the burden of infectious diseases, particularly in developed countries (Armstrong et al., 1999). Globally, however, infectious diseases remain a leading cause of death (Wang et al., 2021). Reflecting this global trend, Southeast Asia faces a particularly high burden: it has the third-largest HIV epidemic worldwide, carries over a quarter of the global tuberculosis burden, and experiences the second-highest incidence of malaria among all WHO regions (Arinaminpathy et al., 2021).
Emerging infectious diseases (EIDs) are newly recognized or recently increased diseases; while re-emerging infectious diseases (REIDs) are previously controlled diseases that have resurged. Alongside these, neglected tropical diseases (NTDs) are a diverse group of conditions caused by a variety of pathogens (including viruses, bacteria, parasites, fungi, and toxins) and associated with devastating health, social, and economic consequences (WHO, 2025a). NTDs are mainly prevalent among impoverished communities in tropical areas, although some have a much larger geographical distribution (WHO, 2025a). Despite control efforts, EIDs, REIDs, and NTDs continue to appear intermittently and pose significant threats to human health (Tabish, 2009). Southeast Asia’s tropical climate, combined with frequent storms and flooding, facilitates the spread of vector-borne diseases such as dengue, malaria, and schistosomiasis, as well as NTDs including lymphatic filariasis, schistosomiasis, and leptospirosis (Hotez et al., 2015).
The persistence of infectious diseases in the region represents an ongoing health and human security concern that could be more effectively addressed through strengthened regional collaboration (Caballero-Anthony, 2018). Within the ASEAN Post-2015 Health Development Agenda, addressing hazards and emerging threats, including communicable diseases, neglected tropical diseases, and emerging and re-emerging infectious diseases is a key priority.
In this context, locally generated, context-specific evidence on infectious diseases is critical to improving prevention, control, and health system resilience across Southeast Asia. Investing in high-quality research and innovation can generate actionable insights, inform public health policy, strengthen tools and interventions, and support the development of products and strategies that enhance preparedness and response to infectious disease threats. Amid these realities, several key infectious disease challenges shape the regional landscape
Vulnerable Communities and Emerging Infectious Disease: Communicable, emerging and re-emerging, zoonotic, neglected tropical, and vaccine-preventable diseases remain major health threats across Southeast Asia.
Despite notable progress in recent years, including reductions in HIV- and malaria-related deaths and expanded tuberculosis (TB) treatment coverage, South-East Asia continues to bear a significant share of the global communicable disease burden (Arinaminpathy et al., 2021; Roche et al., 2018). The region hosts the third-largest HIV epidemic globally and the highest TB burden, accounting for more than a quarter of global cases. Malaria incidence is the second highest among all WHO regions, highlighting the continued vulnerability of populations to communicable diseases.
Moreover, malnutrition and other underlying health challenges exacerbate this burden, leaving communities particularly susceptible to neglected tropical diseases (NTDs) and emerging infections such as dengue, chikungunya, Japanese encephalitis, and influenza outbreaks (Hotez et al., 2015; Wang et al., 2021). Drug-resistant infections also remain a serious threat, causing thousands of neonatal deaths annually and undermining the effectiveness of life-saving antibiotics across the region (Arinaminpathy et al., 2021; Tabish, 2009).
Building on these vulnerabilities, zoonotic diseases, illnesses transmitted between animals and humans, form a major component of emerging infectious diseases (EIDs) in South-East Asia.Many are vector-borne, involving arthropods such as mosquitoes, and pose increasing challenges for public health. Human activities that disrupt ecosystems, including urbanization, deforestation, and intensive farming, have created conditions conducive to the emergence and re-emergence of pathogens (Borham et al., 2025). Wildlife remains the source of the majority of zoonotic EIDs, with studies estimating that 71.8% originate from wild animals, while non-wildlife sources, including livestock, account for the remainder (Rahman et al., 2020).
These risks are further magnified by global connectivity and rapid human mobility which accelerate the spread of infectious diseases, making outbreaks harder to control and emphasizing the need for strong regional and international cooperation (Financial Times, 2017). Surveillance and early detection of novel pathogens are critical, particularly in areas where humans and animals interact closely, as these interfaces are often hotspots for disease spillover (Borham et al., 2025; NASA, 2024). Disruptions to ecological balance not only foster new disease emergence but also amplify the health risks associated with known pathogens.
Climate change compounds these interconnected risks. Rising temperatures, shifting rainfall patterns, and extreme weather events alter habitats and vector dynamics, expanding the geographic range and seasonality of many zoonotic pathogens (Cunningham et al., 2017). Monitoring human activities, zoonotic transmission cycles, and environmental changes is essential for preparing for future threats and strengthening the resilience of health systems in the region (NASA, 2024).
Furthermore, Vaccine-Preventable Diseases (VPDs) continue to impose a heavy burden, with Vietnam reporting over 20,000 suspected measles cases in 2024 and Thailand experiencing a surge from 38 cases in 2023 to 7,507 in 2024 (Borger, 2025). Neglected tropical diseases persist as significant public health challenges across the 11 Southeast Asian countries, while zoonotic diseases affect over two billion people globally each year, causing approximately two million deaths (Sun et al., 2024).
Addressing these interconnected threats requires comprehensive efforts to strengthen disease prevention and control, expand immunisation and public health outreach, intensify NTD control and elimination, and integrate human, animal, and environmental health strategies. Such interventions are essential to reducing disease burden, protecting vulnerable populations, and building resilient and equitable health systems across Southeast Asia.
Outbreak Preparedness and Response: Southeast Asia remains highly vulnerable to infectious disease outbreaks, underscoring the need for strengthened preparedness, surveillance, and rapid response systems.
The COVID-19 pandemic significantly disrupted infectious disease control in Southeast Asia, reducing TB service coverage, slowing malaria prevention, and contributing to stalled progress against NTDs—reflected in the 1.62 billion people needing NTD interventions in 2022, a 26% decrease from 2010 and far from WHO’s 2030 targets (Caballero-Anthony, 2018; McFee, 2018; WHO NTD Road Map 2021–2030).
Vaccine inequities were pronounced: only about 30% of people in low-income countries were fully vaccinated compared with over 70% in high-income countries, with additional exclusion affecting an estimated 1.3 million undocumented migrant workers in Thailand (Sbarra et al., 2023; Khai, 2023). Although laboratories rapidly expanded testing capacity, major gaps in biosafety, genomic surveillance, and workforce readiness limited overall response effectiveness (Borham et al., 2025; Duke-NUS Medical, 2024). Overcrowded and poorly ventilated shelters further drove respiratory and vector-borne transmission during emergencies (Vikas, 2020; Harrison & Williams, 2016).Together, these challenges illustrate how health emergencies amplify existing weaknesses and highlight the need for resilient health systems and equitable access to essential services (Borham et al., 2025).
The region continues to be a hotspot for emerging infectious diseases due to ecological, agricultural, and demographic shifts that increase opportunities for pathogen spillover. Intensified rice and pig farming, combined with gaps in vaccination programs and surveillance, heightens the risk of Japanese encephalitis in countries such as Cambodia, Indonesia, Laos, and Myanmar (Erlanger et al., 2009). Most human pathogens originate as zoonoses, yet animal health surveillance in much of the region is underdeveloped and poorly integrated with human health systems (Butler, 2006). These factors collectively limit early detection and hinder coordinated responses to emerging threats.
Weak surveillance and laboratory systems continue to constrain outbreak preparedness across Southeast Asia, with limitations such as inadequate resources, fragile laboratories, insufficient policies, and poor intersectoral coordination (Narain & Bhatia, 2010). A Duke-NUS Medical study (2024) found that only about half of countries have integrated pathogen genomic surveillance into national plans, underscoring the need to strengthen diagnostic networks and embed genomic tools. Surveillance remains the backbone of disease control, yet persistent gaps, including incomplete reporting and limited diagnostic capacity, still hinder early detection and response (Borham et al., 2025; Butler, 2006; Putthasri et al., 2009). Although countries such as Vietnam, Thailand, Indonesia, Cambodia, Malaysia, and the Philippines have strengthened laboratory networks and coordination mechanisms, but decentralised systems, reporting gaps, and parallel programmes continue to limit effectiveness (International Federation of Red Cross and Red Crescent Societies, 2009; Narain & Bhatia, 2010).
Recent major outbreaks exposed both resilience and vulnerability in the region’s health systems. While laboratories adapted to rapidly increasing demand, gaps in workforce, biosafety, funding, and coordination undermined effective response (Borham et al., 2025). These lessons reinforce the importance of long-term investment in integrated surveillance systems, robust laboratory capacity, and cooperative regional mechanisms.
Zoonotic diseases, which account for most emerging human pathogens, pose additional challenges where intensified agriculture, underdeveloped animal health surveillance, and limited integration with human health systems hinder early detection and coordinated response (Erlanger et al., 2009; Butler, 2006; Rahman et al., 2020).
To enhance outbreak preparedness and response, regional systems must prioritise integrated surveillance, robust early-warning and rapid-response capacities, strengthened laboratory and workforce investments, and deeper cross-border cooperation. These measures are central to enabling faster detection, more coordinated responses, and more resilient and equitable health systems across Southeast Asia.
Disaster Health Management: Climate-related disasters are straining health systems in Southeast Asia and intensifying infectious disease risks.
As climate change intensifies the severity and frequency of natural disasters, Southeast Asian countries face heightened infectious disease risks and greater demands on health systems (Sethi et al., 2023; WHO, 2025b). Human activity and environmental feedback create a vicious cycle, driving new ecological risks and shifts in infectious disease dynamics (Wang et al., 2021). Evidence shows that flooding and other climate-related shocks increase the burden of infectious food- and water-borne diseases such as cholera, as well as zoonoses that emerge through changing ecosystems (Hotez et al., 2015; Arinaminpathy et al., 2021). These pressures highlight how disaster health management is not only about emergency response, but also about strengthening systemic resilience against overlapping environmental and health shocks.
The health impact of disasters is significant and unevenly distributed, with developing countries bearing the brunt due to limited resources, weak infrastructure, and inadequate preparedness systems (Watson et al., 2007). For instance, hospital data from Thailand, Vietnam, and other countries indicate that each additional day of tropical cyclone exposure increased hospitalisations by 9% for all infectious diseases, 13% for intestinal infections, and 22% for dengue (Rockström et al., 2024). Health services are often unable to meet increased demand during disasters, a challenge worsened by damaged facilities, lost equipment, disrupted logistics, and injuries or deaths among healthcare personnel (Lippi et al., 2010; Hariri-Ardebili, 2020).
Post-disaster conditions, such as disrupted hygiene, environmental hazards, and stress, further elevate infectious disease risks (Izumikawa, 2019). Climate change and environmental degradation are increasing the frequency and severity of floods, storms, and other hazards, which in turn raise the burden of water- and food-borne diseases, as well as vector- and zoonotic-borne infections (Hotez et al., 2015; Arinaminpathy et al., 2021; Wang et al., 2021). These overlapping crises exacerbate vulnerabilities, with overcrowded shelters, strained logistics, and overburdened health workers compounding both disaster response and infectious disease control (Vikas, 2020; Harrison & Williams, 2016; Sohrabizadeh et al., 2021).
Strengthening climate-resilient primary healthcare, integrating data and surveillance systems, building workforce capacity, and improving coordinated disaster response planning are crucial for managing the health impacts of overlapping environmental and infectious disease threats (B-Lajoie et al., 2023; Borham et al., 2025). These interventions help ensure continuity of care, support rapid and effective responses to concurrent hazards, and reinforce the resilience of health systems across Southeast Asia.
Antimicrobial Resistance and Vaccine Coverage: Rising antimicrobial resistance and persistent immunisation inequities are critical threats to health security across Southeast Asia, requiring integrated strategies for prevention, surveillance, and equitable access.
The emergence and spread of antimicrobial resistance (AMR) in the region are driven by demographic, environmental, and public health system factors. Irrational drug use, weak health systems with limited regulation, and the widespread availability of counterfeit or substandard medicines have facilitated the evolution of resistant strains (Newton et al., 2003; Coker et al., 2008). The growing prevalence of antibiotic-resistant bacteria (ARB) across human, animal, and environmental settings further underscores AMR as a multisectoral challenge (Podolsky, 2018).
Malaria remains a major concern, with reduced susceptibility to artemisinins, an antimalarial drug, in Cambodia raising global alarm, although comprehensive surveillance data are still limited (Newton et al., 2003). Beyond malaria, resistance affects multiple pathogens, including multidrug-resistant tuberculosis, which remains a significant challenge in low-resource settings where routine monitoring is scarce (Newton et al., 2003). A systematic review also highlights the regional spread of multidrug-resistant Klebsiella pneumoniae across Cambodia, Thailand, Hong Kong, Laos, and Nepal, causing severe bloodstream infections and emphasizing weak regional surveillance and data-sharing capacity (Wallinga et al., 2015). AMR continues to inflict substantial mortality, morbidity, and economic loss across the 11 countries in the WHO South-East Asia (SEA) Region (Sihombing et al., 2023).
Despite heightened awareness and ongoing initiatives, progress against AMR remains fragmented. Capacity gaps, limited funding, weak regulatory systems, and slow behavioral change continue to hinder response efforts (Sihombing et al., 2023). Rising drug resistance in countries including Bangladesh, Indonesia, Nepal, Sri Lanka, and Thailand underscores the urgent need for coordinated regional strategies, stronger surveillance, and robust antimicrobial stewardship.
Inappropriate antibiotic use including inadequate dosing, self-medication, use for non-bacterial infections, and poor adherence, remains a major driver of ARB across human, veterinary, and agricultural settings (Subramaniam & Girish, 2020). Evidence from Indonesia shows persistently suboptimal antibiotic prescribing and widespread self-medication, reinforcing the need for improved stewardship and public education (Limato et al., 2022). Because AMR affects humans, animals, and the environment, regionally tailored research and integrated interventions are essential (Di Carlo et al., 2025; Newton et al., 2003; Coker et al., 2008). Sustained investment in surveillance, stewardship, and cross-border collaboration is critical to strengthening regional resilience (Wallinga et al., 2015; Sihombing et al., 2023; JPIAMR, n.d.; Kelly et al., 2016).
Alongside AMR, inequities in vaccine coverage remain a major public health concern that compound infectious disease risks.A meta-analysis found that children in the poorest wealth quintile and those whose mothers lack formal education are each 27% less likely to be fully vaccinated than their wealthier or more educated counterparts, contributing to persistent outbreaks and undermining herd immunity (Manji et al., 2023).
Vaccine inequities continue to expose major gaps in health system capacity and coverage, disproportionately affecting low-income groups. In many low-income countries, only about 30% of people are fully vaccinated, compared with over 70% in high-income countries, due to limited manufacturing, procurement challenges, service delivery constraints, and weak health system infrastructure (Sbarra et al., 2023). In Southeast Asia, undocumented migrant populations face additional barriers: in Thailand, an estimated 1.3 million undocumented migrant workers remain excluded from vaccination because of insurance and legal obstacles (Khai, 2023). These inequities amplify the risks posed by infectious diseases and AMR, particularly among vulnerable populations, and highlight the urgent need for inclusive and equitable vaccination strategies (Manji et al., 2023; Sbarra et al., 2023; Khai, 2023).
In light of these challenges and priorities, there is a critical need to address AMR and vaccine inequities in tandem by investing in antimicrobial stewardship, strengthening AMR surveillance systems, and implementing targeted, inclusive vaccination programs. Together, these efforts can reduce disease burden, curb the spread of resistant infections, protect vulnerable populations, and build resilient, equitable health systems across Southeast Asia.
This enduring epidemic makes clear that infectious diseases in Southeast Asia are not isolated events, but a complex, persistent crisis shaped by social, environmental, and systemic forces. Meeting these challenges demands long-term commitment to prevention, preparedness, and equitable care, ensuring that the region is better protected against current threats and those yet to emerge.
References
- Adisasmito, W. (2010). Health system and pandemic influenza preparedness: Results from a rapid situational analysis (RSA) in Jakarta and Bali. Outbreak, Surveillance and Investigation Reports, 1(1), 1–9.
- Alshammari, F., Alqahtani, M., Alshammari, M., Alshammari, R., & Alshammari, T. (2023). The impact of climate change on public health: A review of global responses and challenges. Healthcare, 11(19), 1946. https://doi.org/10.3390/healthcare11101946
- Arinaminpathy, N., Sinha, A., Anvikar, A. K., Joseph, A. K., Kang, G., Frost, I., Jain, J. J., Goel, N., Hira, S., Pawar, S., & Laxminarayan, R. (2021). Infectious diseases in the South-East Asia region. One Health Trust. https://onehealthtrust.org/publications/reports/infectious-diseases-in-the-south-east-asia-region/
- Armstrong, G. L., Conn, L. A., & Pinner, R. W. (1999). Trends in infectious disease mortality in the United States during the 20th century. JAMA, 281(1), 61–66. https://doi.org/10.1001/jama.281.1.61
- B-Lajoie, M.-R., Craven, M., Rochford, C., Walker, O., & Wilson, M. (2023, December 6). Future-proofing health systems for climate risks and pandemics. McKinsey & Company. https://www.mckinsey.com/industries/social-sector/our-insights/future-proofing-health-systems-for-climate-risks-and-pandemics
- Borger, J. (2025, May 7). Measles cases hit six-year high in South Korea amid outbreaks across South-East Asia. The Guardian. https://www.theguardian.com/world/2025/may/07/measles-cases-hit-six-year-high-in-south-korea-amid-outbreaks-across-south-east-asia
- Borham, A., Abdel Motaal, K., ElSersawy, N., Ahmed, Y. F., Mahmoud, S., Musaibah, A. S., & Abdelnaser, A. (2025). Climate change and zoonotic disease outbreaks: Emerging evidence from epidemiology and toxicology. International Journal of Environmental Research and Public Health, 22(6), 883. https://doi.org/10.3390/ijerph22060883
- Butler, D. (2006). Disease surveillance needs a revolution. Nature, 440(7080), 6–7. https://doi.org/10.1038/440006a
- Caballero-Anthony, M. (2018). Health and human security challenges in Asia: New agendas for strengthening regional health governance. Australian Journal of International Affairs, 72(6), 602–616. https://doi.org/10.1080/10357718.2018.1517939
- Cardil, A., & De-Miguel, S. (2020). COVID-19 jeopardizes the response to coming natural disasters. Safety Science, 130, 104861. https://doi.org/10.1016/j.ssci.2020.104861
- Carter, A., Msemburi, W., Sim, S. Y., Gaythorpe, K. A. M., Lindstrand, A., & Hutubessy, R. C. W. (2021). Modeling the impact of vaccination for the immunization agenda 2030: Deaths averted due to vaccination against 14 pathogens in 194 countries from 2021–2030. SSRN. https://doi.org/10.2139/ssrn.3830781
- Coker, R., Atun, R., & McKee, M. (Eds.). (2008). Health systems and the challenge of communicable diseases. Open University Press.
- Cunningham, A. A., Daszak, P., & Wood, J. L. N. (2017). One Health, emerging infectious diseases and wildlife: Two decades of progress? Philosophical Transactions of the Royal Society B: Biological Sciences, 372(1725), 20160167. https://doi.org/10.1098/rstb.2016.0167
- Di Carlo, P., Serra, N., Collotta, O., Colomba, C., Firenze, A., Aprea, L., Distefano, S. A., Cortegiani, A., Giammanco, G., Fasciana, T. M. A., Virruso, R., Capuano, A., Sergi, C. M., & Cascio, A. (2025). The influence of the seasonal variability of Candida spp. bloodstream infections and antifungal treatment: A Mediterranean pilot study. Antibiotics, 14(5), 452. https://doi.org/10.3390/antibiotics14050452
- Duke-NUS Medical School. (2024, September 24). Outbreak detection under-resourced in Asia, study finds. ScienceDaily. https://www.sciencedaily.com/releases/2024/09/240924123008.html
- Erlanger, T. E., Weiss, S., Keiser, J., Utzinger, J., & Wiedenmayer, K. (2009). Past, present, and future of Japanese encephalitis. Emerging Infectious Diseases, 15(1), 1–7. https://doi.org/10.3201/eid1501.080311
- Financial Times. (2017, March 7). The long road to elimination of neglected tropical diseases. https://www.ft.com/content/a7904aae-0266-11e7-aa5b-6bb07f5c8e12
- Hariri-Ardebili, M. A. (2020). Living in a multi-risk chaotic condition: Pandemic, natural hazards and complex emergencies. International Journal of Environmental Research and Public Health, 17(16), 5635. https://doi.org/10.3390/ijerph17165635
- Harrison, C. G., & Williams, P. R. (2016). A systems approach to natural disaster resilience. Simulation Modelling Practice and Theory, 65, 11–31. https://doi.org/10.1016/j.simpat.2016.02.008
- Holmes, A. H., Moore, L. S., Sundsfjord, A., Steinbakk, M., Regmi, S., Karkey, A., Guerin, P. J., & Piddock, L. J. (2016). Understanding the mechanisms and drivers of antimicrobial resistance. The Lancet, 387(10014), 176–187. https://doi.org/10.1016/S0140-6736(15)00473-0
- Hotez, P. J., Bottazzi, M. E., Strych, U., et al. (2015). Neglected tropical diseases among the Association of Southeast Asian Nations (ASEAN): Overview and update. PLoS Neglected Tropical Diseases, 9(8), e0003575. https://doi.org/10.1371/journal.pntd.0003575
- Izumikawa, K. (2019). Infection control after and during natural disaster. Acute Medicine & Surgery, 6(1), 5–11. https://doi.org/10.1002/ams2.367
- International Federation of Red Cross and Red Crescent Societies. (2009). Legal preparedness for responding to disasters and communicable disease emergencies: Study report. International Federation of Red Cross and Red Crescent Societies / Asian Development Bank.
- JPIAMR. (n.d.). Research funding datahub. Joint Programming Initiative on Antimicrobial Resistance. https://www.jpiamr.eu/resources/amr-knowledge-hub/research-funding-datahub/
- Kaviprawin, M., Raju, M., Sakthivel, M., & Ramalingam, A. (2025). Zoonotic disease outbreaks reported under India's Integrated Disease Surveillance Programme, 2018–2023: A cross-sectional analysis of national surveillance data. The Lancet Regional Health – Southeast Asia, 21, 100601. https://doi.org/10.1016/j.lansea.2025.100601
- Khai, T. S. (2023). Socio-ecological barriers to access COVID-19 vaccination among Burmese irregular migrant workers in Thailand. Journal of Migration and Health, 8, 100194. https://doi.org/10.1016/j.jmh.2023.100194
- Kelly, R., Zoubiane, G., Walsh, D., Ward, R., & Goossens, H. (2016). Public funding for research on antibacterial resistance in the JPIAMR countries, the European Commission, and related European Union agencies: A systematic observational analysis. The Lancet Infectious Diseases, 16(4), 431–440. https://doi.org/10.1016/S1473-3099(15)00366-1
- Khai, T. S. (2023). Socio-ecological barriers to access COVID-19 vaccination among Burmese irregular migrant workers in Thailand. Journal of Migration and Health, 8, 100194. https://doi.org/10.1016/j.jmh.2023.100194
- Limato, R., Lazarus, G., Dernison, P., Mudia, M., Alamanda, M., Nelwan, E. J., Sinto, R., Karuniawati, A., van Doorn, H. R., & Hamers, R. L. (2022). Optimizing antibiotic use in Indonesia: A systematic review and evidence synthesis to inform opportunities for intervention. The Lancet Regional Health – Southeast Asia, 2, Article 100013. https://doi.org/10.1016/j.lansea.2022.05.002
- Lippi, G., Favaloro, E. J., & Plebani, M. (2010). Laboratory medicine and natural disasters: Are we ready for the challenge? Clinical Chemistry and Laboratory Medicine, 48(5), 573–575. https://doi.org/10.1515/CCLM.2010.148
- Manji, K., Perera, S., Hanefeld, J., Vearey, J., Olivier, J., Gilson, L., & Walls, H. (2023). An analysis of migration and implications for health in government policy of South Africa. International Journal for Equity in Health, 22, Article 82. https://doi.org/10.1186/s12939-023-01862-1
- McFee, R. B. (2018). Emerging infectious diseases overview. Disease-a-Month, 64(5), 163–169. https://doi.org/10.1016/j.disamonth.2018.01.002
- Narain, J., & Bhatia, R. (2010). The challenge of communicable diseases in the WHO South-East Asia Region. Bulletin of the World Health Organization, 88(3), 162. https://doi.org/10.2471/BLT.09.065169
- NASA. (2024). Evidence on climate change. NASA Science. https://science.nasa.gov/climate-change/evidence/
- Newton, P. N., Dondorp, A., Green, M., Mayxay, M., & White, N. J. (2003). Counterfeit artesunate antimalarials in Southeast Asia. The Lancet, 362(9388), 169. https://doi.org/10.1016/S0140-6736(03)13872-X
- Nguyen-Viet, H., Chotinun, S., Schelling, E., Widyastuti, W., Khong, N. V., Kakkar, M., Beeche, A., Jing, F., Khamlome, B., Tum, S., & others. (2017). Reduction of antimicrobial use and resistance needs sectoral-collaborations with a one health approach: Perspectives from Asia. International Journal of Public Health, 62(Suppl 1), 3–5. https://doi.org/10.1007/s00038-017-0941-5
- Noedl, H., Se, Y., Schaecher, K., Smith, B. L., Socheat, D., & Fukuda, M. M. (2008). Evidence of artemisinin-resistant malaria in western Cambodia. The New England Journal of Medicine, 359(24), 2619–2620. https://doi.org/10.1056/NEJMc0805011
- Pagès, F., Maison, D., & Faulde, M. (2018). Current control strategies for infectious diseases in low-income countries. In B. Roche, H. Broutin, & F. Simard (Eds.), Ecology and evolution of infectious diseases: Pathogen control and public health management in low-income countries. Oxford University Press. https://doi.org/10.1093/oso/9780198789833.003.0002
- Podolsky, S. H. (2018). The evolving response to antibiotic resistance (1945–2018). Palgrave Communications, 4, 124. https://doi.org/10.1057/s41599-018-0181-3
- Precha, N., Sukmai, S., Hengbaru, M., Chekoh, M., Laohaprapanon, S., Makkaew, P., & Che Dom, N. (2024). Knowledge, attitudes, and practices regarding antibiotic use and resistance among health science and non-health science university students in Thailand. PLOS ONE, 19(1), e0296822. https://doi.org/10.1371/journal.pone.0296822
- Previti, S., Di Chio, C., Ettari, R., & Zappalà, M. (2022). Dual inhibition of parasitic targets: A valuable strategy to treat malaria and neglected tropical diseases. Current Medicinal Chemistry, 29(17), 2952–2978. https://doi.org/10.2174/0929867328666210810125309
- Putthasri, W., Lertiendumrong, J., Chompook, P., Tangcharoensathien, V., & Coker, R. (2009). Capacity of Thailand to contain an emerging influenza pandemic. Emerging Infectious Diseases, 15(3), 423–432. https://doi.org/10.3201/eid1503.080872
- Rahman, M. T., Sobur, M. A., Islam, M. S., Ievy, S., Hossain, M. J., El Zowalaty, M. E., Rahman, A. T., & Ashour, H. M. (2020). Zoonotic diseases: Etiology, impact, and control. Microorganisms, 8(9), 1405. https://doi.org/10.3390/microorganisms8091405
- Roche, B., Baldet, T., & Simard, F. (2018). Infectious diseases in low-income countries: Where are we now? In B. Roche, H. Broutin, & F. Simard (Eds.), Ecology and evolution of infectious diseases: Pathogen control and public health management in low-income countries. Oxford University Press. https://doi.org/10.1093/oso/9780198789833.003.0001
- Rockström, J., Steffen, W., Noone, K., Persson, Å., Chapin, F. S., Lambin, E., Lenton, T. M., Scheffer, M., Folke, C., Schellnhuber, H. J., Nykvist, B., de Wit, C. A., Hughes, T., van der Leeuw, S., Rodhe, H., Sörlin, S., Snyder, P. K., Costanza, R., Svedin, U., ... & Corell, R. W. (2024). A just world on a safe planet: A Lancet Planetary Health–Earth Commission report on Earth-system boundaries, translations, and transformations. The Lancet Planetary Health, 8(9), e642–e659. https://doi.org/10.1016/S2542-5196(24)00158-X
- Sbarra, A. N., Carter, E. D., Chang, H., Sim, S. Y., Msemburi, W., Gaythorpe, K. A. M., Lindstrand, A., & Hutubessy, R. C. W. (2023). Deaths averted by vaccination against 14 pathogens in 194 countries between 2021 and 2030: A modelling study. The Lancet, 402(10403), 1456–1466. https://doi.org/10.1016/S0140-6736(23)01589-4
- Sihombing, B., Bhatia, R., Srivastava, R., Aditama, T. Y., Laxminarayan, R., & Rijal, S. (2023). Response to antimicrobial resistance in South-East Asia Region. The Lancet Regional Health – Southeast Asia, 18, 100306. https://doi.org/10.1016/j.lansea.2023.100306
- Stärk, K. D. C., Arroyo Kuribreña, M., Dauphin, G., Vokaty, S., Ward, M. P., Wieland, B., & Lindberg, A. (2015). One Health surveillance–More than a buzz word? Preventive Veterinary Medicine, 120(1), 124–130. https://doi.org/10.1016/j.prevetmed.2015.04.019
- Sethi, Y., Kaka, N., Patel, N., Roy, D., Chopra, H., & Emran, T. B. (2023). Environmental correlates of infectious diseases in South-East Asia: A perspective on the missed link. New Microbes and New Infections, 53, 101118. https://doi.org/10.1016/j.nmni.2023.101118
- Subramaniam, G., & Girish, M. (2020). Antibiotic resistance—A cause for reemergence of infections. Indian Journal of Pediatrics, 87, 937–944. https://doi.org/10.1007/s12098-019-03180-3
- Sun, Z.-S., Wan, E.-Y., Agbana, Y. L., Zhao, H.-Q., Yin, J.-X., Jiang, T.-G., Li, Q., Fei, S.-W., Wu, L. B., Li, X.-C., Zhang, Q.-Y., Liu, J.-S., Gu, S.-Y., Guo, Z.-Y., Xue, J.-B., Han, L.-F., Zhang, X.-X., Xia, S., Welburn, S. C., Okpeku, M., ... Kassegne, K. (2024). Global One Health index for zoonoses: A performance assessment in 160 countries and territories. iScience, 27(6), 109297. https://doi.org/10.1016/j.isci.2024.109297
- Sohrabizadeh, S., Yousefian, S., Bahramzadeh, A., & Vaziri, M. H. (2021). A systematic review of health sector responses to the coincidence of disasters and COVID-19. BMC Public Health, 21, 709. https://doi.org/10.1186/s12889-021-10806-9
- Tabish, S. A. (2009). Recent trends in emerging infectious diseases. International Journal of Health Sciences (Qassim), 3(2), V–VIII. https://pmc.ncbi.nlm.nih.gov/articles/PMC3068824/
- Touch, S., Grundy, J., & Hills, S. (2009). The rationale for integrated childhood meningoencephalitis surveillance: A case study from Cambodia. Bulletin of the World Health Organization, 87(4), 320–324. https://doi.org/10.2471/BLT.08.052951
- Vikas. (2020). The Southwest monsoon during COVID-19 pandemic: A potential concern. Asia-Pacific Journal of Public Health, 32(6–7), 374–375. https://doi.org/10.1177/1010539520944729
- Wallinga, D., Rayner, G., & Lang, T. (2015). Antimicrobial resistance and biological governance: Explanations for policy failure. Public Health, 129(10), 1314–1325. https://doi.org/10.1016/j.puhe.2015.05.007
- Wang, W.-H., Thitithanyanont, A., Urbina, A. N., & Wang, S.-F. (2021). Emerging and re-emerging diseases. Pathogens, 10(7), 827. https://doi.org/10.3390/pathogens10070827
- Watson, J. T., Gayer, M., & Connolly, M. A. (2007). Epidemics after natural disasters. Emerging Infectious Diseases, 13(1), 1–5. https://doi.org/10.3201/eid1301.060779
- World Health Organization. (2024). Global report on neglected tropical diseases 2024: Stronger together, towards 2030. https://www.who.int/teams/control-of-neglected-tropical-diseases/global-report-on-neglected-tropical-diseases-2024
- World Health Organization. (2015). Global action plan on antimicrobial resistance. WHO Regional Office for the Eastern Mediterranean. https://www.emro.who.int/fr/health-topics/drug-resistance/global-action-plan.html
- World Health Organization. (n.d.). Neglected tropical diseases. WHO South-East Asia Regional Office. https://www.who.int/southeastasia/health-topics/neglected-tropical-diseases
- World Health Organization. (2025a, May 30). Neglected tropical diseases. https://www.who.int/health-topics/neglected-tropical-diseases#tab=tab_1
- World Health Organization. (2025b). Climate change. https://www.who.int/southeastasia/health-topics/climate-change
Subscribe To
Our Newsletter
Stay up to date with our latest funding,
news, events, and announcements.




